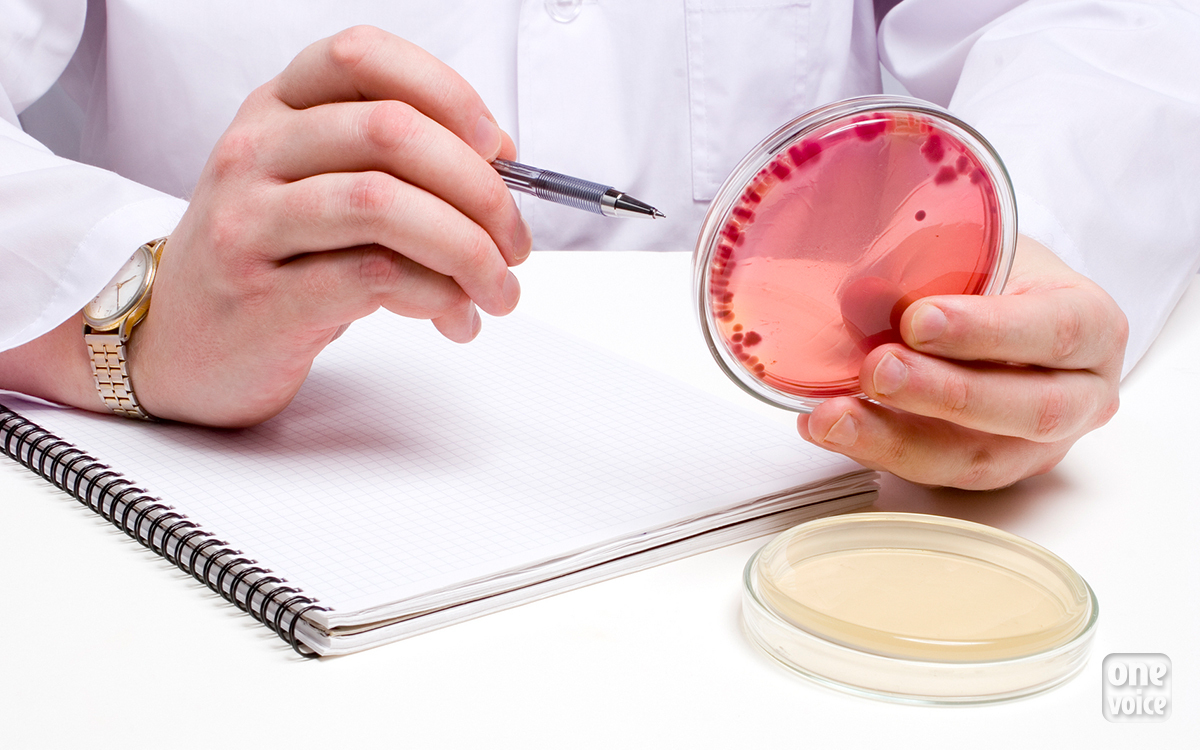

Les actualités de One Voice
Filtrer
Tous nos combats
Toutes nos enquêtes
Toutes typologies